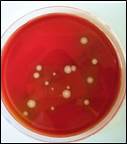

Kompetenz und Erfahrung in Tiergesundheit und Lebensmittelsicherheit
![]()
Die Amerikanische Faulbrut (AFB) ist eine ansteckende, anzeigepflichtige Tierseuche, die eine ernstzunehmende Bedrohung für Bienenvölker darstellt. Nehmen Bienen-Larven Sporen des Erregers auf, so vermehrt sich das Bakterium zunächst im Darm der Larven. Einige Tage später durchbrechen die Erreger die Darmwand und töten die Larve durch Besiedelung der Leibeshöhle der ab. Die toten Larven werden vollständig zersetzt. Die Larvenüberreste enthalten dann Millionen neuer Sporen.
Die Sporen sind stabil gegenüber hohen und tiefen Temperaturen sowie vielen chemischen Desinfektionsmitteln. In Honig können sie bis zu 10, in den eingetrockneten Schorfen verendeter Larven problemlos Jahrzehnte lang infektiös bleiben.
Befinden sich Sporenquellen im Umfeld von Bienenvölkern, so werden diese angeflogen und Sporen ins Heimatvolk eingetragen. Dies ist nicht zu verhindern, weshalb es auch nicht möglich ist Infektionen zu vermeiden. Durchaus möglich ist jedoch die Feststellung eines Sporeneintrages noch vor dem klinischen Ausbruch der Seuche mittels bakteriologischer Untersuchung von Futterkranzproben. Bei frühzeitiger Feststellung ist eine Sanierung der betroffenen Völker problemlos möglich, wohingegen Völker mit klinischem Ausbruch der AFB i.d.R. abgetötet werden müssen. Weiterhin muss im letzteren Fall ein Sperrbezirk mit erheblichen Restriktionen für die betroffenen ausgerufen werden. Bei einem Labornachweis des Erregers ohne klinische Symptome im Bienenvolk erfolgt dies nicht.
Eine umfassende Beschreibung von Symptomen und Biologie der AFB steht im Artikel zu Bakteriellen Infektionen im Bereich Bienenkrankheiten: Symptome und Gegenmaßnahmen zur Verfügung. Berichte zu den Ergebnissen des AFB-Monitorings ab 2017 finden Sie in der Rubrik Fachbeiträge oder am Ende dieses Themenkomplexes.
Grundsätzlich können Futterkranzproben immer dann entnommen werden, wenn die Witterung ein Öffnen der Bienenvölker zulässt. Dennoch existieren ungeeignete, weniger geeignete sowie besonders gut geeignete Zeitpunkte für eine Beprobung.
Als ungeeignet für die Futterkranzbeprobung müssen Zeiträume mit herrschenden Massentrachten bezeichnet werden, denn dann werden täglich größere Mengen Nektar in die Bienenvölker eingetragen. Werden unter diesen Bedingungen Futterkranzproben gezogen, so handelt es sich vielfach um mehr oder weniger frisch eingetragenen Nektar. Hier sind keine Sporen des Erregers der AFB zu erwarten. Sollten sich in den Völkern doch geringe Sporen-Mengen befinden, so kommt es zu starken Verdünnungseffekten und deshalb reduzierter Nachweisbarkeit des Erregers. Folglich sind Futterkranzanalysen, in denen keine Sporen feststellbar sind, nach intensivem Nektareintrag kaum aussagekräftig. Gleiches gilt für eine Beprobung nach vorhergehender Fütterung von Bienenvölkern.
Außerhalb der genannten Zeiträume ist in der Regel ein aussagekräftiges Ergebnis der Futterkranzanalyse zu erwarten. Die Aussagekraft lässt sich aber noch erheblich steigen, indem die Probennahme in trachtarme Phasen verlegt wird (optimalerweise zwischen Honigernte im Sommer und der Auffütterung für den Winter). Hier findet der größte Austausch zwischen Bienenvölkern statt (Räuberei). Weiterhin werden auch andere "alternative Futterquellen", wie z.B. bienenzugänglicher (Auslands-) Honig o.ä. intensiv beflogen. Somit erhalten die Ergebnisse der Futterkranzanalysen auch eine gewisse Aussagekraft über mögliche Sporenquellen im Flugradius der beprobten Völker.
Für systematische Beprobungen ganzer Regionen mit dem Ziel einer Flächenaussage (AFB-Monitoring, s.u.) sind nur Beprobungen in diesen Zeiträumen sinnvoll.

Bienenvölker stehen über Verflug und Räuberei in ständigem Austausch untereinander. Werden Bienenstände in Abständen von 5-10 km beprobt, so kann mittels weniger Proben die Verbreitung von Sporen des Erregers der Amerikanischen Faulbrut (Paenibacillus larvae) in einer ganzen Region abgeschätzt werden. Dieses Verfahren bietet sich z.B. für die Überwachung eines Verbandsgebiets von Imker-Kreisverbänden an. Sollten Sie im Zuge eines Monitorings eine größere Anzahl an Proben einsenden wollen, informieren Sie uns bitte bereits im Vorfeld über Ihr Vorhaben. Das Vorgehen bei einem Flächenmonitoring zur Vorbeugung der Amerikanischen Faulbrut ist im Merkblatt Faulbrutscreening beschrieben.
Merkblatt: Faulbrutscreening
Informationen zur Probennahme finden Sie in der Liste unserer Merkblätter
Sollten in Ihren Völkern Sporen von Paenibacillus larvae nachweisbar sein, besteht auf jeden Fall Handlungsbedarf. Je nach Anzahl der Sporen im Futter und Zustand der Völker kann die Seuchenbekämpfung jedoch durchaus völkererhaltend durchgeführt werden (Kunstschwarmverfahren etc.). Im folgenden Artikel können Sie sich über den Umgang mit sporenbelasteten Völkern informieren.
Artikel: Umgang mit durch Sporen von Paenibacillus larvae belasteten Völkern
Sind Sporen des Erregers der AFB oder klinische Symptome eines Ausbruchs der Seuche in Bienenvölkern feststellbar, so müssen - neben der sofortigen Anzeige bei der zuständigen Veterinärbehörde - angemessene Gegenmaßnamen eingeleitet werden. Welche Maßnahmen konkret eingesetzt werden sollten oder müssen ist von der jeweiligen Situation abhängig (s.o. Merkblatt: Umgang mit Sporen von Paenibacillus larvae belasteten Völkern).
Von Zentraler Bedeutung ist, dass Desinfektions- bzw. Entseuchungsarbeiten und die Sanierung von Bienenvölkern fachgerecht durchgeführt werden. Zusätzlich müssen alle Sporenquellen in der Umgebung beseitigt werden, um einen Sporen-Neueintrag zu verhindern. Nur dann sind die Maßnahmen auch erfolgsversprechend.
Alle Sanierungsmaßnahmen an P. larvae-positiven Bienenvölkern einer betroffenen Region sollten möglichst gleichzeitig (innerhalb 1-2 Tage) durchgeführt werden, da noch nicht sanierte Völker sonst Sporenquellen für bereits behandelte Völker darstellen können. Bei größeren Völkerzahlen ist hierbei eine durchdachte Organisation der Sanierungs- und Entseuchungs-Arbeiten empfehlenswert. Bewährte Vorgehensweisen zur Organisation umfangreicherer Sanierungsaktionen sind im folgenden Artikel zusammengefasst:
Artikel: Organisation von Sanierungs- und Entseuchungsmaßnahmen
Die genauen Kennzahlen und Parameter zur sicheren Entseuchung von Bienenprodukten und Betriebsmitteln sind in den Empfehlungen des Friedrich-Löffler-Instituts zur Desinfektion bei Tierseuchen gelistet.
Sollten Sie keine Erfahrung mit Desinfektion und Völkersanierung haben, wird empfohlen, die regionalen Bienensachverständigen oder entsprechend erfahrene Imkernde um Unterstützung zu bitten. Auch die staatlichen Fachberater für Bienenzucht stehen beratend zur Verfügung.
Auf der Homepage des Instituts für Bienenkunde und Imkerei der LWG Veitshöchheim sind alle für die Tötung und Sanierung von Bienenvölkern sowie die Entseuchung von Materialien relevanten Punkte im Bereich Seuchenbekämpfung bei der Amerikanischen Faulbrut ausführlich beschrieben. Darüber hinaus stehen dort umfassende Informationen zu behördlich angeordneten Maßnahmen im Falle eines Ausbruchs der AFB, Sperrbezirks-Untersuchungen und -Aufhebung etc. zur Verfügung.

Da die Sanierung von Bienenständen insbesondere bei größeren Völkerbeständen mit hohem Materialaufwand verbunden ist, wurden in einigen Regierungsbezirken bzw. Imkerverbänden Bayerns sogenannte Bienengesundheits-Mobile (BIG-Mobile) angeschafft. Hierbei handelt es sich um PKW-Anhänger, die alle für umfangreiche Sanierungsmaßnahmen notwendigen Geräte und Materialien enthalten. Die BIG-Mobile können i.d.R. gegen eine geringe Gebühr ausgeliehen werden. Sofern nicht im Heimatbezirk im Einsatz, ist meist auch ein Verleihen der Ausrüstung in andere Regierungsbezirke möglich.
Standorte und Kontakt zu den Betreuern von BIG-Mobilen: BIG-Mobile in Bayern
Der TGD Bayern e.V. führt die Untersuchung von Futterkranzproben hinsichtlich Sporen des Erregers der AFB (Paenibacillus larvae) gemäß der "Amtlichen Sammlung von Verfahren zur Probenahme und Untersuchung von Untersuchungsmaterial tierischen Ursprungs im Hinblick auf anzeigepflichtige Tierseuchen“ (Amtliche Methodensammlung)" des Friedlich Löffler Instituts durch. Die Expertise des TGD Bayern e.V. in der Untersuchung von Futterkranzproben wird durch regelmäßige Teilnahme an den Ringversuchen des Nationalen Referenzlabors für Bienenkrankheiten nachgewiesen (Zertifikate: 2018, 2021).
Die Berichte über die Ergebnisse des AFB-Monitorings des BGD im TGD Bayern e.V. stehen in der Rubrik Fachbeiträge unter Jahres- und Abschlussberichte des BGD zum Download zur Verfügung.